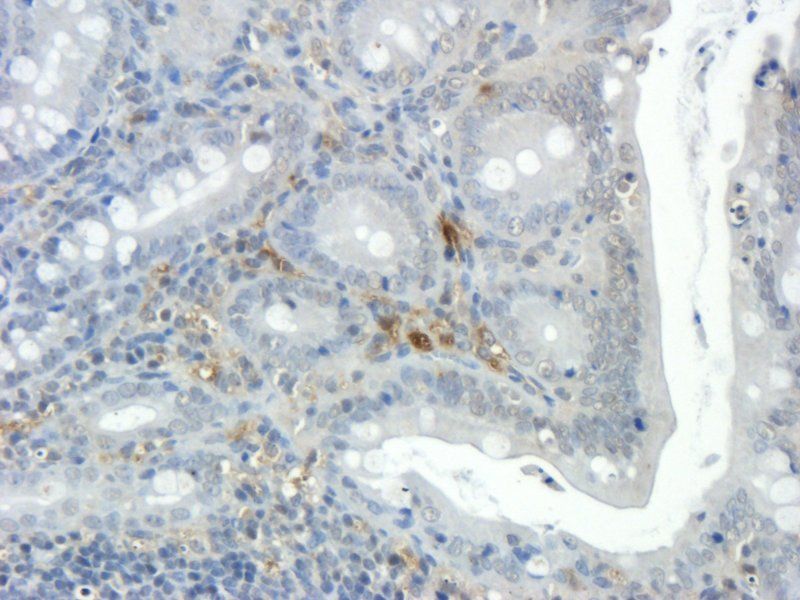
产品细节图片1

相关产品推荐更多 >
万千商家帮你免费找货
0 人在求购买到急需产品
- 详细信息
- 文献和实验
- 技术资料
- 抗体名:
Integrin beta 1 antibody抗体
- 抗体英文名:
Integrin beta 1 antibody
- 靶点:
Integrin beta 1
- 浓度:
- 100 μg (in 200 μl): 0.5 mg/ml- 200 μg (in 400 μl): 0.5 mg/ml
- 应用范围:
ELISA, ICC, IF, IHC-P
- 宿主:
Rabbit
- 适应物种:
Bovine, Canine, Equine, Gallus, Human, Mouse, Porcine, Rat, Sheep
- 保质期:
6-12个月
- 抗原来源:
详询
- 目录编号:
orb251610
- 级别:
科研级
- 库存:
88
- 供应商:
biorbyt
- 标记物:
Unconjugated
- 克隆性:
Polyclonal
- 形态:
10 mM PBS, 0.02% sodium azide
- 亚型:
IgG
- 免疫原:
KLH conjugated synthetic peptide derived from human Integrin beta 1. Please contact us for the exact immunogen sequence. The peptide is available as orb374870.
- 规格:
100 ug
别名:anti-beta1 integrin antibody, anti-CD29 antibody, anti-Fibronectin receptor subunit beta antibody, anti-FNRB antibody, anti-Glycoprotein IIa antibody, anti-GP IIa antibody, anti-GPIIA antibody, anti-Integrin beta-1 antibody, anti-integrin VLA-4 beta subunit antibody, anti-Integrin, beta 1 (fibronectin receptor, beta polypeptide, antigen CD29 includes MDF2, MSK12) antibody, anti-ITB1_HUMAN antibody, anti-ITGB1 antibody, anti-MDF2 antibody, anti-MSK12 antibody, anti-OTTHUMP00000019420 antibody, anti-Very late activation protein, beta polypeptide antibody, anti-VLA BETA antibody, anti-VLA-4 subunit beta antibody, anti-VLA-BETA antibody, anti-VLAB antibody, anti-VLAbeta antibody
免疫原:KLH conjugated synthetic peptide derived from human Integrin beta 1. Please contact us for the exact 免疫原 sequence. The peptide is available as orb374870.
分子量:88 kDa
应用稀释比例:IF/ICC: 1:200, IHC-P: 1:200
纯度:Polyclonal antibodies are purified by peptide affinity chromatography
保存说明:Maintain refrigerated at 2-8°C for up to 2 weeks. For long term storage store at -20°C in small aliquots to prevent freeze-thaw cycles.
Pubmed:38010560
Entrez:3688
UniProt ID:P49134, P05556, P09055
Note:For research use only.

风险提示:丁香通仅作为第三方平台,为商家信息发布提供平台空间。用户咨询产品时请注意保护个人信息及财产安全,合理判断,谨慎选购商品,商家和用户对交易行为负责。对于医疗器械类产品,请先查证核实企业经营资质和医疗器械产品注册证情况。
文献和实验2-1 integrin分子的结构(示意图) 注:a .integrin分子电镜下所见(模式图),黑区部分显示integrin分子α、β亚单位所 组成的球部,为配体结合域; b.integrin分子的结构模式图,显示出α亚单位的二价阳离子(Mg2+ )结合区和α、 β亚单位的重复序列。 (一)粘合素分子的基本结构
;Ⅱbβ3的表达是血小板内酪氨酸磷酸化过程发生的必要条件,αⅡbβ3不表达或其与配体的作用被阻断均可阻碍血小板内的酪氨酸磷酸化过程。但αⅡbβ3单独作用并不足以引起酪氨酸磷酸化,而只是作为其它刺激活化因素的必要辅助条件。对其它细胞进行的研究结果同样提示integrin分子参与细胞内酪氨酸磷酸化的过程,如使KB细胞(一种癌细胞系)表达的α3β1分子发生交联后可以发现细胞内一种分子量为115~130kDa的分子发生酪氨酸磷酸
CD29 分子 CD29 常用单克隆抗体或代号: 4B4;(integrin b 1,FNRb ) 主要表达细胞: 广泛分布 [AS] 分子质量(kDa)和结构: gp130血小板,GPⅡa 功 能: 与ECM粘合,细胞间粘附,结合VCAM- 1(CD106) CD29 Aka platelet GPIIa, beta-1 integrin, fibronectin receptor Positive staining
技术资料暂无技术资料 索取技术资料











